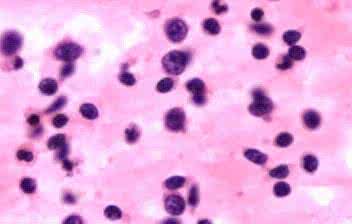
过敏性紫癜是用中医还是西医,过敏性紫癜西医治好还是中医治好

过敏性紫癜是因机体对某些过敏物质发生快速型变态发应或抗原-抗体复合物沉积而引起广泛毛细血管通透性和脆性增高以至出血的一种血管性出血性疾病。本病又称出血性毛细血管中毒症、许兰--亨诺综合征。本病临床特征除皮肤紫癜外,常有不同程度关节痛、腹痛及肾炎等表现,少数伴有血管神经性水肿。
过敏性紫癜的治疗,临床上的治疗方案呈现多样化,主分中医及西医。
上海紫癜疾病研究院的李钰医生表示:本病若采用单纯中医或单纯西医治疗,近期疗效较好,但常易反复发作,特别是有紫癜肾炎者,若使用皮质激素,可先用中大剂量控制病情,待症状消失,即予减至小剂量,效果显著,但疗效维持却十分有限,且明显的治疗目的是在于暂时的控制压制,终究不是治本的方法。
采用中医中药治疗疗效肯定,但一般起效较慢,且不对症的中医会使得疾病治疗效果适得其反,这也是需要强调的一点,李医生表示,中医若能配合西医的治疗,则既可发挥中药治本抗病毒、调节免疫失衡之特长,又可减轻病患以往西药激素或免疫*制剂抑**之毒副作用。

很多患者会提问到,为什么过敏性紫癜这么容易复发,我一感冒疾病就出现起伏的情况,这是怎么回事呢?
李医生表示,此病必须强调去除病灶的重要性,病灶不除,将导致病情反复发作。病灶分为外因和内因,外因之中,又以感染,特别是上呼吸道感染占首位,其次是食物,如牛奶、蛋类、鱼虾、豆类、蟹、香菇等食品,若考虑为过敏因素,在彻底治愈本病前,应当禁食。而内因是病人的免疫系统缺陷,知晓外内因,针对性治疗,修复免疫缺陷,控制饮食,护理得当,疾病想要康复并不难。
